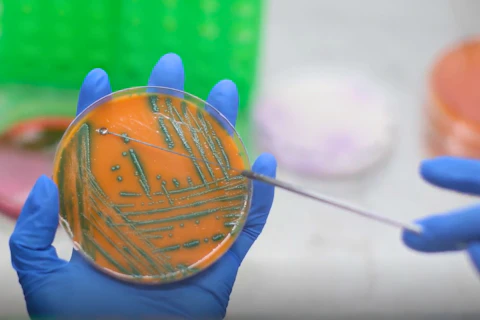
sgs

Tipo de noticias
Fecha de publicación
Tema
64 resultados encontrados

SGS en GFSI Conference 2026: Food Safety es responsabilidad de todos
Claves para fortalecer la inocuidad alimentaria y el acceso a mercados internacionales.
Leer más
¿Cómo se evalúa el inventario de la Huella de Carbono? Guía completa de la ISO 14064
Aprende cómo se evalúa la Huella de Carbono de una empresa bajo la ISO 14064 y cómo funciona la verificación de emisiones de gases de efecto invernadero.
Leer más
Food Risk Snapshot 2026: riesgos emergentes en la inocuidad alimentaria en América Latina
Conozca los principales riesgos alimentarios detectados por los laboratorios de SGS LATAM: patógenos, PFAS, micotoxinas y nuevos contaminantes que están impactando la seguridad alimentaria y las exportaciones.
Leer más
SGS en América Latina: tecnología, precisión y confianza para decisiones críticas en la industria
Conoce cómo SGS en América Latina combina tecnología, análisis de laboratorio, inspección y certificación para ayudar a las industrias a tomar decisiones seguras y basadas en evidencia.
Leer más
El ABC de la Huella del Carbono, glosario de términos
Descubre los conceptos clave de la Huella de Carbono, verificación ISO 14064 y emisiones GEI en este glosario esencial para empresas en Latinoamérica.
Leer más
Normativa ambiental en Latinoamérica
Conoce cómo se regula el monitoreo ambiental en Latinoamérica, qué exigen las autoridades en agua, aire y suelo, y por qué el cumplimiento normativo ambiental es clave para las empresas.
Leer más
¿Cómo elegir una empresa de monitoreo ambiental en Latinoamérica?
Descubre cómo elegir servicios de monitoreo ambiental en Latinoamérica considerando acreditación, experiencia, tecnología y cumplimiento normativo ambiental.
Leer más
¿Qué es el monitoreo ambiental y por qué es crucial en Latinoamérica?
Descubre qué es el monitoreo ambiental, por qué es crucial en Latinoamérica y cómo impacta el cumplimiento normativo, la sostenibilidad y la continuidad operativa.
Leer más
SGS y 44west: ciencia en acción para proteger la biodiversidad durante el desafío oceánico más extremo
Descubre cómo SGS apoyó el triunfo de 44west combinando deporte extremo con análisis de eDNA (ADN Ambiental) y microplásticos para monitorear biodiversidad y salud marina.
Leer más
Wind Services: Cómo reducir incidentes en trabajos en altura y offshore en energía eólica
Wind Services - Buenas prácticas para reducir incidentes en trabajos en altura y offshore durante la operación y mantenimiento en Latinoamérica.
Leer más